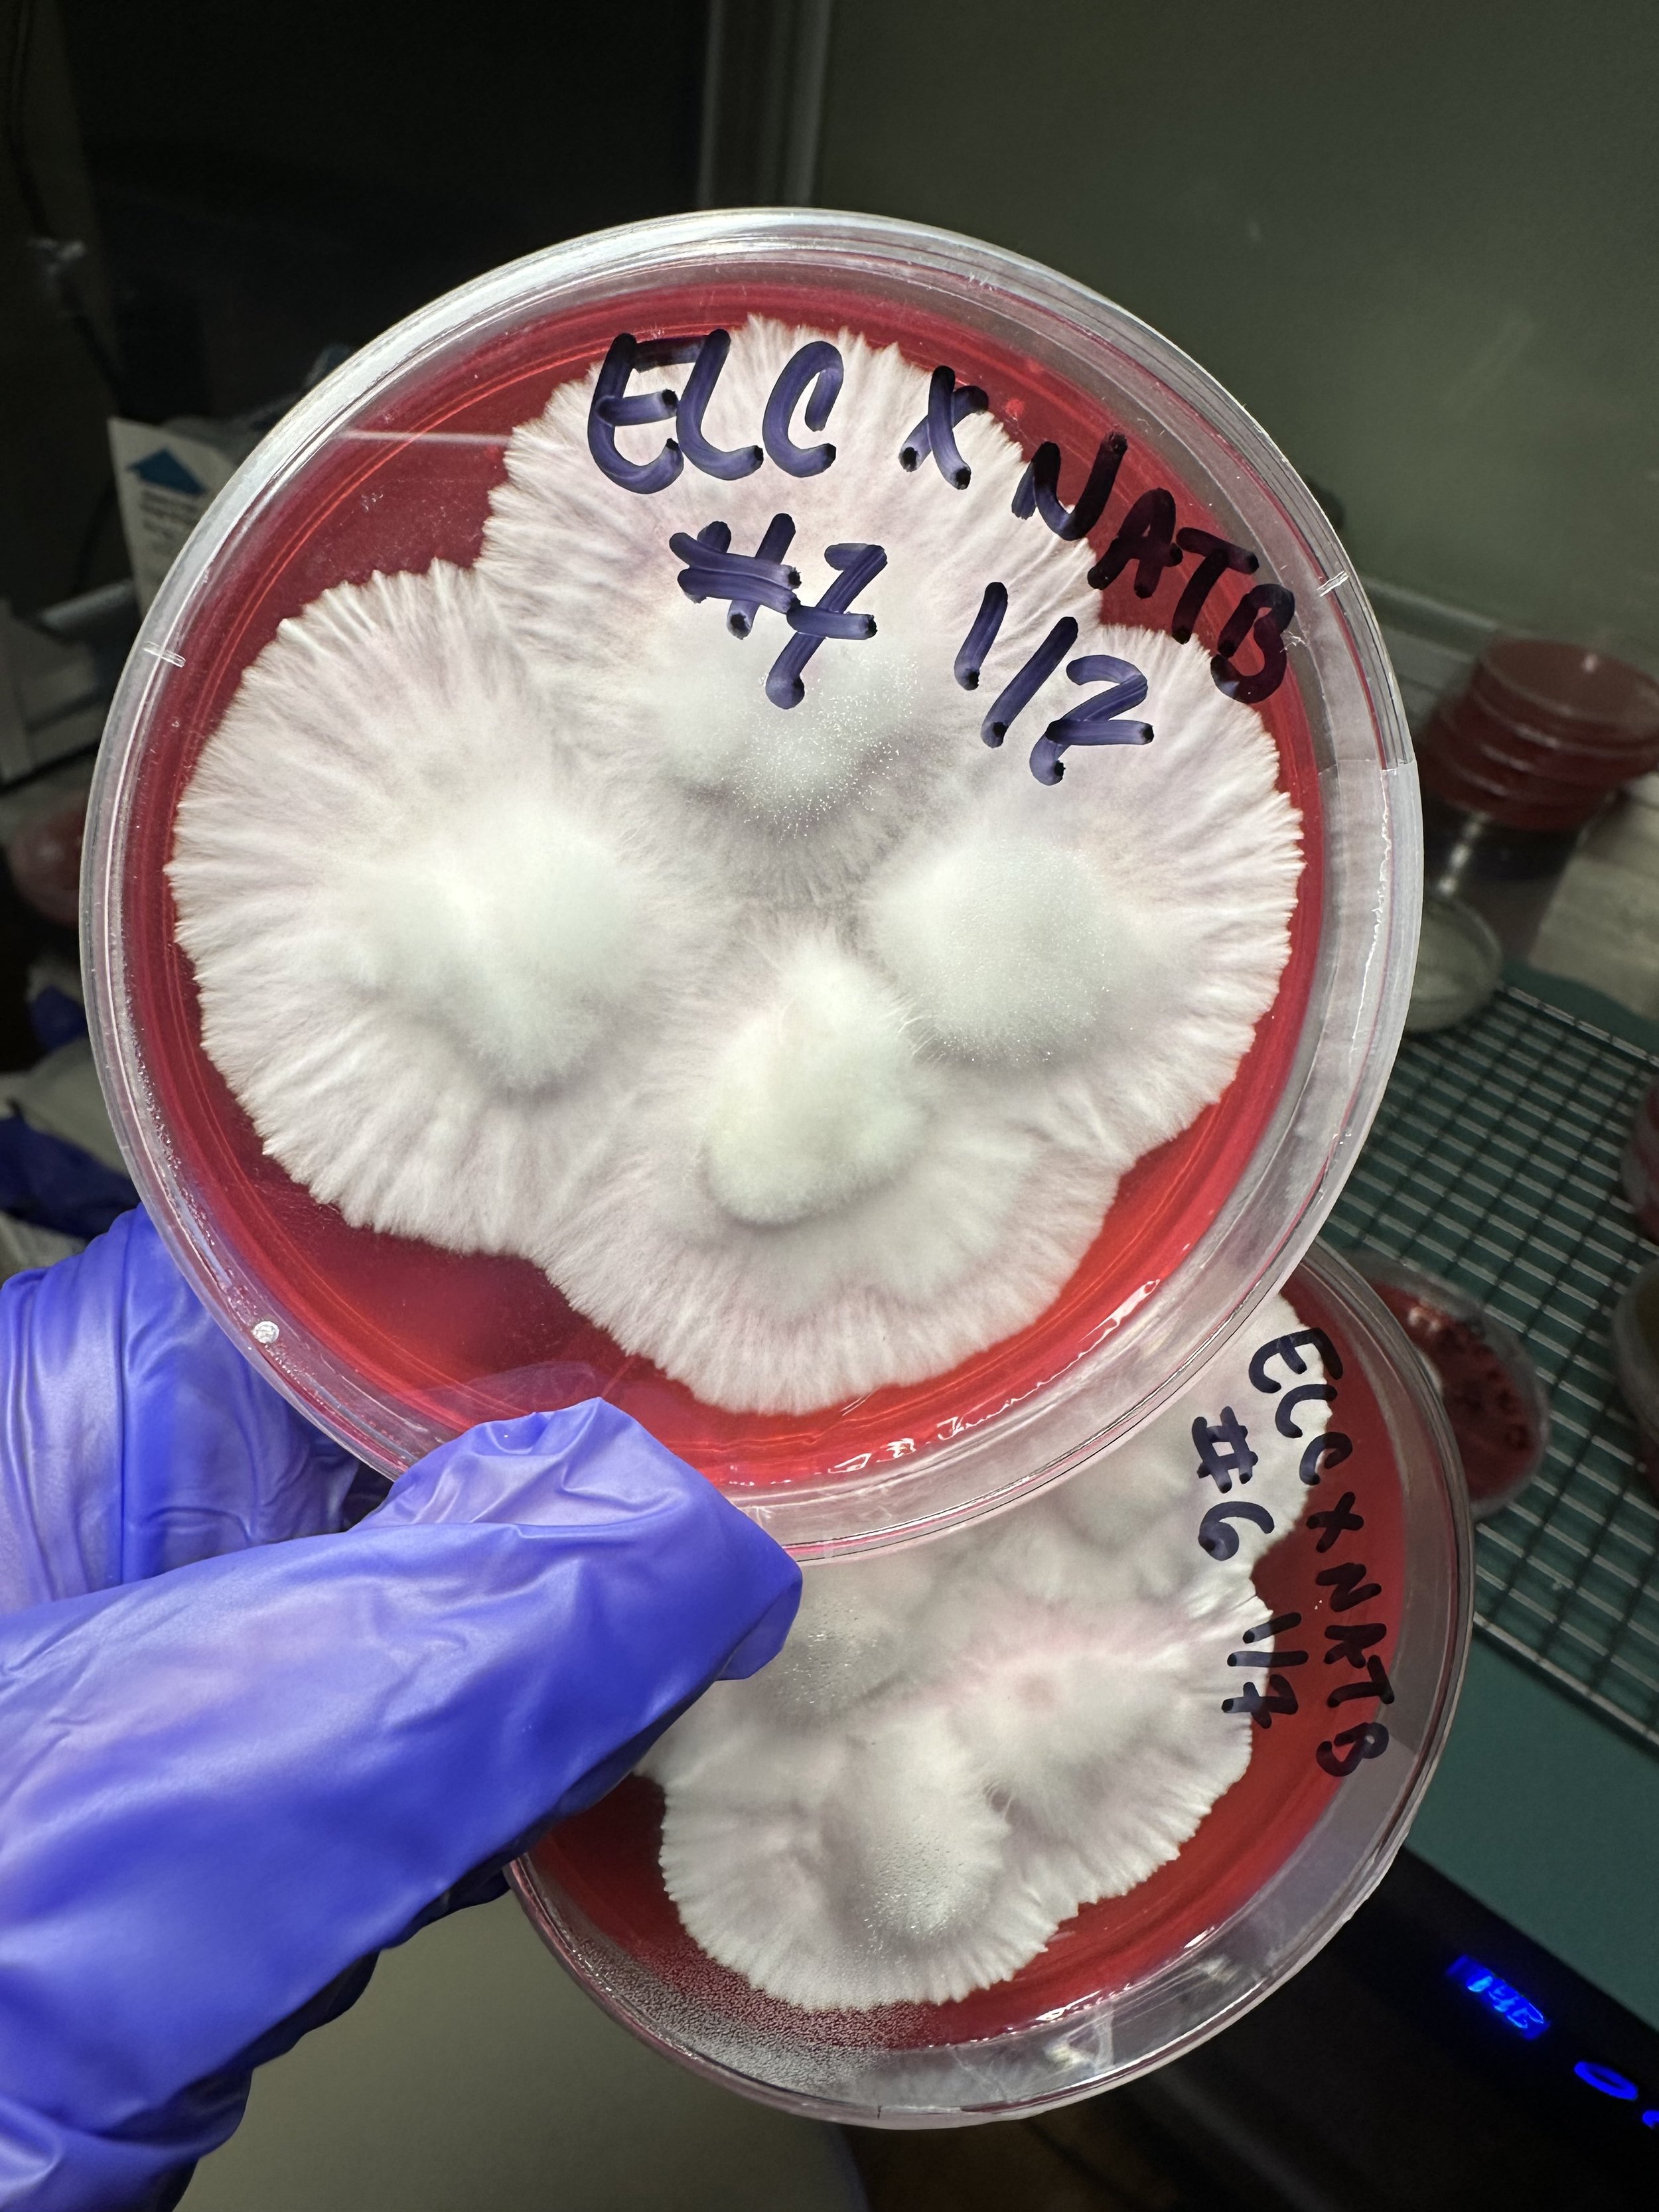

About
Matka Góra [MAT-kah GOO-rah] means "mother mountain" in Polish. The name reflects the importance of mountains in my ancestral story, as sources of water, safety, orientation, and deep connection to place. When I see mountains on the horizon, I feel grounded and know where I am. These landscapes held special significance for my ancestors, and the places I am drawn to call home echo their lands. Mountains are where I go to forage and find healing.
My personal origin story is also tied to Loowit, or Lawetlat'la, a volcano known as Mt. St. Helens in southwest Washington, sacred to the Cowlitz, Klickitat, and Yakama peoples. Her names mean "smoking mountain" or "lady of fire." My parents were trapped by the ash cloud during her 1980 eruption, and I owe my conception to that extraordinary event. I was born the following spring as part of a small localized baby boom. Loowit stands as an emblem of resilience and nature's power to heal. Plants like lupin and fireweed accelerated the recovery of the local ecosystem by decades. In Loowit, I find a lesson in renewal and hope, even amid destruction and loss.
Below is a list of some of the projects I am involved in for Matka Góra. I invite you to join me in this journey of discovery and remembrance.
Featured Efforts
The Matka project explores the development of novel Psilocybe crosses intended to support gentler, more accessible experiences within spiritually oriented practices outside conventional frameworks. Rooted in a faith-based perspective that understands personal suffering and transformation through a spiritual lens, this work is part of a broader expression of religious inquiry and practice. It is conducted as an expression of sincerely held religious belief and is intended to align with protections afforded under the Religious Freedom Restoration Act (RFRA), and is not intended to diagnose, treat, or make claims regarding medical or health conditions.
Matka Breeding Project

The Krasna project is a research and ecological initiative focused on fostering beneficial Amanita species through inoculating the roots of young, compatible tree seedlings. By supporting these intricate mycorrhizal relationships, the project aims to strengthen forest ecosystems and promote regenerative connections between fungi and trees. Establishing these partnerships is challenging because Amanita species require precise ecological conditions, compatible hosts, and time to form stable associations. The Krasna Project explores best practices for nurturing these delicate relationships, blending careful observation, ecological research, and a deep respect for the interconnectedness of life.
